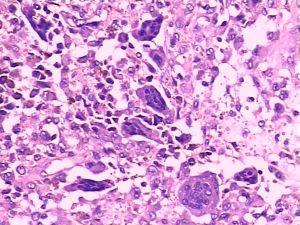
顱骨巨細胞瘤

概述
顱骨巨細胞瘤流行病學
顱骨巨細胞瘤病因
發病機制
顱骨巨細胞瘤腫瘤由單核間質細胞及散在多核巨細胞組成,間質細胞是腫瘤的主要成分,它決定腫瘤的性質。53%病人的骨巨細胞瘤周圍可見到大片梭形細胞增生,梭形細胞沒有惡性腫瘤的特性,其出現有否與預後無關。
Jaffe根據組織學特點將腫瘤分為三級,分別為良性潛在惡性和惡性。良性發病率占此類疾病的絕對優勢。腫瘤一般生長緩慢,很少發生轉移,而在局部浸潤生長。腫瘤溶骨性很強,但對軟組織則無破壞。腫瘤內多有出血區域。
腫瘤可呈實質性或囊腫性兩種。實質性腫瘤切面呈灰白色或黃褐色 常可見出血及壞死區,如有大片出血,則呈紅棕色或暗褐色 腫瘤間質血管豐富者,腫瘤生長活躍。囊性腫瘤則形成多房性或單發較大囊腔。有的囊腔內壁僅有一層薄膜 囊內充滿咖啡色、黃褐色等漿液性或血性液體。
臨床表現
病程緩慢,大小不等的囊狀物突入顱內引起相應症狀。早期腫瘤體積小時病人可無症狀,腫瘤達到一定體積時引起腦神經麻痹和頭痛。如發生在蝶骨和鞍區附近 發生於顱中窩底的巨細胞瘤可能出現相應部位的臨床各表現。腫瘤可能表現出很強的侵犯性 甚至造成病人死亡。
併發症
蝶骨和鞍區附近的腫瘤可引起視力障礙、視野缺損以及動眼神經、展神經和三叉神經受損症狀。發生於顱中窩底的巨細胞瘤可引起反覆感染及聽力下降。
診斷
顱骨巨細胞瘤鑑別診斷:
顱內巨細胞瘤應與好發部為常見的其他腫瘤鑑別,如脊索瘤、大的垂體瘤、鼻咽癌以及轉移癌等。由於顱骨巨細胞瘤惡性程度相對較高 所以在組織病理上應該與發生部位相同的含巨細胞的腫物相鑑別,包括巨細胞修復性肉芽腫、甲狀旁腺功能亢進、成軟骨細胞瘤、骨纖維結構不良和動脈瘤樣骨囊腫巨細胞修復性肉芽腫可侵犯面頰、顎部以及顎外區域的骨質,巨細胞修復性肉芽腫有不規則片狀分布的巨細胞,成纖維膠原基質上有骨質化生。巨細胞修復性肉芽腫的一致特徵是圍繞巨細胞的細胞呈細長形。甲狀旁腺功能亢進與巨細胞修復性肉芽腫的組織學特徵相同 必須通過實驗室檢查來鑑別二者。成軟骨細胞瘤比巨細胞修復性肉芽腫更少見,它的特點是局部軟骨分化增生,形成結節樣或帶狀的深染上皮樣細胞巨細胞和血鐵質色素顆粒分散分布動脈瘤樣骨囊腫和骨纖維結構不良可以通過梭形細胞增生的成纖維特性,以及骨質生成的結構,與骨巨細胞瘤區分偶爾骨巨細胞瘤與轉移癌病理區分困難,需要尋找原發灶,明確診斷。巨細胞修復性肉芽腫通常可以通過單純手術治療控制,不需要放射治療。而放療是顱骨巨細胞瘤完整治療的一部分,單獨手術治療不能控制病情的發展。所以鑑別骨巨細胞瘤和巨細胞修復性肉芽腫有重要意義。
檢查
頭顱X線平片其它輔助檢查:
與身體其他部為的骨巨細胞瘤相同 呈單純溶骨性改變,最常見的部位是蝶骨近中線處 軟組織樣腫瘤擴張常見,軟組織影與骨質破壞有關,但影像學上沒有特異性特徵來明確診斷。
頭顱X線平片可分為三種類型:
1.多囊型 不規則多房性骨破壞區,內有殘存粗大骨梁,邊緣銳利規則,呈高密度線條狀影。
2.單囊型 呈膨脹性骨破壞區,瘤內無骨小梁間隔X線檢查如骨囊腫,內外板分離,周圍有高密度骨硬化帶
3.單純骨破壞型 非膨脹性骨破壞無囊腫樣表現
CT表現為均一高密度病灶,不強化或輕微強化。MRI可明確腫瘤的部位及與周圍組織的解剖關係。
治療
以手術治療為主,應儘量做到全切腫瘤。由於腫瘤多位於顱底且血運豐富,並且腫瘤經常有局部侵犯 造成腫瘤全切較為困難。由於現代顯微神經外科手術技術的進步,可以做到更完全的切除。手術後放射治療是有效地局部控制腫瘤的方法。化療有一定的療效。(1)局部切除 如病變部分切除後對功能影響不大,最好完全切除,如腓骨上端、尺骨下端、橈骨上端、手骨、足骨等。
(2)徹底刮除,50%氯化鋅燒灼加植骨術。對鄰近大關節的良性骨巨細胞瘤,如採用單純刮除植骨法,復發率可高達40~70%,所以不少學者採取破壞性的大手術,如連同關節面一起作瘤段切除,然後以屍體骨關節或人工假體置換,此法合併症多,如骨不連線,關節僵直,假體鬆動、感染等,可造成嚴重病廢,甚至導致截肢。其實,所謂復發,乃手術刮除不徹底所致,為了減少復發,我們設計了如下方法:適當暴露腫瘤部位,直視下徹底刮除腫瘤組織,然後以50%氯化鋅周道地燒灼骨壁,以殺滅殘存瘤細胞,經用生理鹽水徹底沖洗乾淨後,再用自體松質骨植骨(必要時植部分同種異體骨)。實驗證明,50%氯化鋅有較強的穿透能力,可殺滅5毫米深處的瘤細胞,且對植骨癒合無不良影響,刮除後的骨殼仍有良好的血液供應,保證了植骨的癒合。另外,關節四周的正常軟組織附著不受任何影響,術後的關節功能得以保證。自1964年來,用此法處理130例骨巨細胞瘤,復發率下降至10%,個別復發病例經用同法處理,仍得到治癒。
(3)切除或截肢 如為惡性,範圍較大,有軟組織浸潤或術後復發,應根據具體情況考慮局部切除或截肢,有的切除腫瘤後失去關節作用。
(4)放射治療 在手術不易達到,或切除後對功能影響過大者,劑量要足夠。有一定療效,少數病人照射後可發生惡變。經手術或放射治療的病人,要長期隨診,注意有無局部復發,惡性改變及肺部轉移。
預後
預後與腫瘤的部位及其組織學特性有關 部位深在、局部侵犯性強的腫瘤破壞性可能極強,造成病人嚴重的殘疾,甚至死亡。